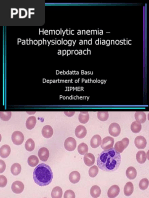

0% found this document useful (0 votes)
153 views3 pagesD-Dimer Assay Kit Overview and Instructions
This document provides instructions for using a D-Dimer assay kit to test for D-Dimer levels in serum or plasma samples. It describes the materials, reagents, assay procedure, quality control measures, and interpretation of results.
Uploaded by
Ajay ChauhanCopyright
© © All Rights Reserved
We take content rights seriously. If you suspect this is your content, claim it here.
Available Formats
Download as PDF, TXT or read online on Scribd
0% found this document useful (0 votes)
153 views3 pagesD-Dimer Assay Kit Overview and Instructions
This document provides instructions for using a D-Dimer assay kit to test for D-Dimer levels in serum or plasma samples. It describes the materials, reagents, assay procedure, quality control measures, and interpretation of results.
Uploaded by
Ajay ChauhanCopyright
© © All Rights Reserved
We take content rights seriously. If you suspect this is your content, claim it here.
Available Formats
Download as PDF, TXT or read online on Scribd